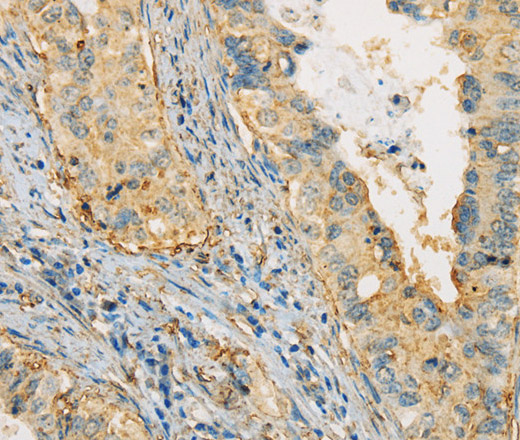
Валидация Elabscience E-AB-14586

| UNIPROT | P06727 |
| Иммуноген | Рекомбинантный белок, соответствующий человеческому APOA4 |
APOA4 Polyclonal Antibody (E-AB-14586)
Реактивность подтвержденная:
человек
Источник (хозяин):
кролик
Валидировано для:
IHC
Характеристики
Публикации
Техническое описание
| Каталожный номер | E-AB-14586 |
| Название антигена | Apolipoprotein A4 (APOA4) |
| UNIPROT | P06727 |
| Иммуноген | Рекомбинантный белок, соответствующий человеческому APOA4 |
| Английские синонимы | ApoA-IV, ApoAIV, Apo-A4 |
Реактивность подтвержденная Нужна другая реактивность? |
человек |
| Источник (хозяин) | кролик |
| Изотип | IgG |
| Клональность | поликлональное |
| Рекомбинантное | нет |
| Готовое к использованию | нет |
| Концентрация | 0.2 мг/мл |
| Конъюгат | нет |
| Валидировано для | IHC Иммуногистохимия |
| Рекомендуемые разведения | IHC 1:25-1:100 |
| Метод очистки | Аффинная хроматография |
| Состав буфера | PBS с 0.05% азид натрия и 50% глицерин, PH7.4 |
| RRID | AB_534727 |
| Условия доставки | термобокс с аккумуляторами холода |
| Условия хранения | Хранить при -20°C - 12 месяцев. Избегать повторяющихся циклов замораживания/оттаивания |
| Срок хранения | 12 месяцев |
| Производитель | Elabscience |
| Ссылка на страницу товара на сайте производителя | https://www.elabscience.com/p-apoa4_polyclonal_antibody-e_ab_14586 |
|
Артикул
|
Наименование |
Производитель
|
|---|
|
Артикул
|
Наименование |
Производитель
|
|---|
|
Артикул
|
Наименование |
Производитель
|
|---|
|
Артикул
|
Наименование |
Производитель
|
|---|
|
Артикул
|
Наименование |
Производитель
|
|---|
|
Артикул
|
Наименование |
Производитель
|
|---|
|
Артикул
|
Наименование |
Производитель
|
|---|
Акции и предложения
Популярные продукты:
Goat Dentin Matrix Protein 1 ELISA kit (E06D0064)
Организм: коза
Rat Catalase ELISA kit (E02C0086)
Организм: крыса
Диапазон определения: 2.5-50 нг/мл
Чувствительность: 0.1 нг/мл
Диапазон определения: 2.5-50 нг/мл
Чувствительность: 0.1 нг/мл
Rabbit Carnosine ELISA kit (E04C0361)
Организм: кролик
Sheep Resistin ELISA kit (E14R0351)
Организм: овца
Диапазон определения: 0.5-10 нг/мл
Чувствительность: 0.1 нг/мл
Диапазон определения: 0.5-10 нг/мл
Чувствительность: 0.1 нг/мл
Rat Resistin ELISA kit (E02R0351)
Организм: крыса
Anti-NKX6-1 Polyclonal Antibody (PHF68201)
Источник (хозяин): кролик
Реактивность подтвержденная: человек, мышь, крыса
Валидировано для: ELISA, IHC, WB
Реактивность подтвержденная: человек, мышь, крыса
Валидировано для: ELISA, IHC, WB